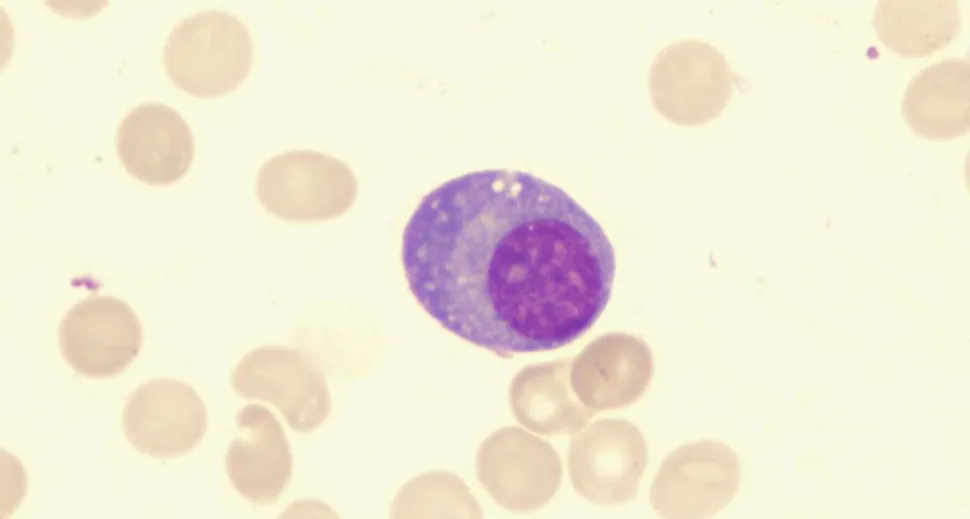
A New Potential Stage of Precursor Condition in Multiple Myeloma image

A New Potential Stage of Precursor Condition in Multiple Myeloma
An earlier precursor condition for multiple myeloma called MGIP has been identified in patients who were being screened for MGUS and smoldering myeloma, using a more sensitive test called mass spectometry.
Catherine Marinac, PhD of Dana Farber Cancer Institute shared results of the PROMISE study at the recent Intercepting Blood Cancers conference. The PROMISE study included 7,622 people that included adults over 40 who were Black or were family members of multiple myeloma patients. The study was screening for the presence of MGUS or smoldering myeloma in these populations. MGUS is a common condition that is found in 3% of people over the age of 50 in the United States and was found to be 3x higher in the Black population.
Using a sensitive test called mass spectrometry from a blood sample, the cutoff to be considered MGUS was a monoclonal protein over .2 grams/liter. The mass spectrometry test is called MALDI-TOF and was provided by The Binding Site for the study.
Interestingly, they found individuals with a monoclonal protein of under .2 g/l and classified described these patients with a new classification called Monoclonal Gammopathy of Indeterminate Significance (MGIP).
Irene Ghobrial, MD of Dana Farber noted that they didn’t want to classify these low level patients as MGUS and confuse everyone. They screened two patients with MGIP and selected CD19 and CD138 cells and found that the two patients actually had lymphomas. Dr. Ghobrial noted that patients with early B cell lymphomas like CLL or follicular lymphoma may not be getting properly diagnosed.
Rafael Fonseca, MD of the Mayo Clinic discussed that the MGIP finding increased with age. There were no racial differences between White and Black patients with MGIP. He noted that if there is a deletion of 6q at the time of MGIP, this typically becomes a condition called Waldenstroms Macroglobulinemia.
DOES MGIP Persist?
MGIP seems to be quite common and in a large percentage of patients, it persists. Using the same MALDI-TOF test, the MGIP persisted in 35% of cases. When using another test called LC-MS (liquid chromatography–mass spectrometry), MGIP persisted in 91% of cases.
Further work will be done to beter understand this condition and how it relates to MGUS, smoldering myeloma and multiple myeloma.
An earlier precursor condition for multiple myeloma called MGIP has been identified in patients who were being screened for MGUS and smoldering myeloma, using a more sensitive test called mass spectometry.
Catherine Marinac, PhD of Dana Farber Cancer Institute shared results of the PROMISE study at the recent Intercepting Blood Cancers conference. The PROMISE study included 7,622 people that included adults over 40 who were Black or were family members of multiple myeloma patients. The study was screening for the presence of MGUS or smoldering myeloma in these populations. MGUS is a common condition that is found in 3% of people over the age of 50 in the United States and was found to be 3x higher in the Black population.
Using a sensitive test called mass spectrometry from a blood sample, the cutoff to be considered MGUS was a monoclonal protein over .2 grams/liter. The mass spectrometry test is called MALDI-TOF and was provided by The Binding Site for the study.
Interestingly, they found individuals with a monoclonal protein of under .2 g/l and classified described these patients with a new classification called Monoclonal Gammopathy of Indeterminate Significance (MGIP).
Irene Ghobrial, MD of Dana Farber noted that they didn’t want to classify these low level patients as MGUS and confuse everyone. They screened two patients with MGIP and selected CD19 and CD138 cells and found that the two patients actually had lymphomas. Dr. Ghobrial noted that patients with early B cell lymphomas like CLL or follicular lymphoma may not be getting properly diagnosed.
Rafael Fonseca, MD of the Mayo Clinic discussed that the MGIP finding increased with age. There were no racial differences between White and Black patients with MGIP. He noted that if there is a deletion of 6q at the time of MGIP, this typically becomes a condition called Waldenstroms Macroglobulinemia.
DOES MGIP Persist?
MGIP seems to be quite common and in a large percentage of patients, it persists. Using the same MALDI-TOF test, the MGIP persisted in 35% of cases. When using another test called LC-MS (liquid chromatography–mass spectrometry), MGIP persisted in 91% of cases.
Further work will be done to beter understand this condition and how it relates to MGUS, smoldering myeloma and multiple myeloma.

about the author
Jennifer Ahlstrom
Myeloma survivor, patient advocate, wife, mom of 6. Believer that patients can contribute to cures by joining HealthTree Cure Hub and joining clinical research. Founder and CEO of HealthTree Foundation.
More on Treatment Advances
Trending Articles





Get the Latest Multiple Myeloma Updates, Delivered to You.
By subscribing to the HealthTree newsletter, you'll receive the latest research, treatment updates, and expert insights to help you navigate your health.